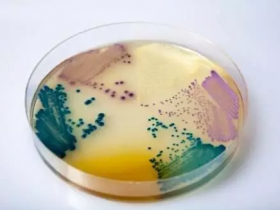
细胞培养基常见成分及功能

经典的培养基有很多种,其中 DMEM、 RPMI 1640、 MEM 、 DMEM/F12 都是应用最广泛的培养基。其他 如 M199 、 IMDM 、 L15培养基等也用于某些细胞的培养。至于选择何种培养基并没有一定的标准,有几点建议可供参考。
经典的培养基有很多种,其中 DMEM、 RPMI 1640、 MEM 、 DMEM/F12 都是应用最广泛的培养基。其他 如 M199 、 IMDM 、 L15培养基等也用于某些细胞的培养。其具体的特征及应用如下:

1、BME细胞培养基
基础Eagle培养基(Basal Medium Eagle),1955年Eagle设计,BSS+12种氨基酸+谷氨酰胺+8种维生素。简单、便于添加,适于各种传代细胞系和特殊研究用,在此基础上改良的细胞培养基品种有MEM、DMEM、IMDM等。
2、MEM细胞培养基
又称低限量Eagle培养基(Minimal Essential Medium),1959年在Eagle's基础培养基(BME)上修改而来,删去赖氨酸、生物素,氨基酸浓度增加,适合多种细胞单层生长,有可高压灭菌品种,是一种最基本、试用范围最广的培养基,但因其营养成分所限,针对生产之特定细胞培养与表达时,并不一定是使用效果最佳或者最经济的培养基。
3、DMEM细胞培养基
DMEM是由Dulbecco改良的Eagle培养基,起初是为小鼠成纤维细胞设计的。DMEM的氨基酸浓度是MEM的两倍,维生素浓度是MEM的4倍,采用双倍的HCO3-和CO2浓度起到更好的缓冲作用。最初的配方中葡萄糖含量为1000 mg/L,后来为了某些细胞的生长需要,将葡萄糖含量又调整为4500 mg/L,这就是大家常说的低糖和高糖了。
低糖适于依赖性贴壁细胞培养,特别适用于生长速度快、附着性较差的肿瘤细胞培养。高糖更适合高密度悬浮细胞培养,也适用于附着性较差,但又不希望它脱离原来生长点的克隆培养,也可用于杂交瘤中骨髓瘤细胞和DNA转染的转化细胞的培养。例如CHO细胞表达生产乙肝疫苗、CHO细胞表达EPO。
4、IMDM细胞培养基
Guilber 和Iscove将Dulbecco' Medium 改良为 Iscove's Medium,用于培养红细胞和巨噬细胞前体。此种培养液含有硒、额外的氨基酸和维生素、丙酮酸钠和HEPES。并用硝酸钾取代了硝酸铁。IMDM还能够促进小鼠B淋巴细胞,LPS刺激的B细胞,骨髓造血细胞,T细胞和淋巴瘤细胞的生长。IMDM为营养非常丰富的培养液,因此可以用于高密度细胞的快速增殖培养。
5、RPMI-1640细胞培养基
Moore等人于1967年在Roswell Park Memorial Institute研制,针对淋巴细胞培养设计,含BSS+21种氨基酸+维生素11种等。现也用于悬浮细胞培养,如哺乳动物、特殊造血细胞、正常或恶性增生的白细胞,杂交瘤细胞的培养,其它像K-562、HL-60、Jurkat、Daudi、IM-9等成淋巴细胞、T细胞淋巴瘤细胞以及HCT-15上皮细胞等均可参考使用。
6、HamF10细胞培养基
1963年Ham设计,含微量元素,可在血清含量低时用,适用于克隆化培养。F10适用于仓鼠、人二倍体细胞,特适于羊水细胞培养。
7、DMEM/F12细胞培养基
Ham's F12是为在低血清浓度下克隆CHO细胞而设计的,现在也广泛应用于克隆形成率的分析及原代培养。F12还可以与DMEM等体积混合使用,得到一种高浓度与成分多样化相结合的产物,这种培养基已应用于许多原代培养及更难养的细胞系的培养。由于营养成分丰富,且可以使用较少血清,故也常作为无血清培养基的基础培养基。
8、M199细胞培养基
1950年Morgan等设计的具有确定化学成分的细胞培养液,即M-199。除BSS外,含有53种成分,为全面培养基,主要用于鸡胚成纤维细胞培养。此培养液必须辅以血清才能支持长期培养。M-199可用于培养多种种属来源的细胞,并能培养转染的细胞。现广泛用于病毒学、疫苗生产。
9、McCoy5A培养基
1959年MeCoy为肉瘤细胞设计,BSS+40种成分。可支持多种(如骨髓、皮肤、肺和脾脏等)的原代移植物的生长,除适于一般的原代细胞培养外,主要用于作组织活检培养、一些淋巴细胞培养以及一些难培养细胞的生长支持。例如Jensen大鼠肉瘤成纤维细胞、人淋巴细胞、HT-29、BHL-100等上皮细胞。
10、L15 细胞培养基
L-15培养液适用于快速增殖瘤细胞的培养,用于在CO2缺乏的情况下培养肿瘤细胞株。此培养液采用磷酸盐缓冲体系,氨基酸组成进一步改良,并由半乳糖替代了葡萄糖。
至于选择何种培养基并没有一定的标准,有几点建议可供参考:
(1)建立某种细胞株所用的培养基应该是培养这种细胞首选的培养基。可以查阅参考文献,或在购买细胞株时咨询。也可以在一些生物公司的网站上搜索,如Invitrogen网站上有一个Cell Line Database的工具,选择你感兴趣的细胞类型,它就会弹出推荐的培养基、血清和转染试剂等,有时还有优化好的转染步骤,很方便。
(2) 其它实验室惯用的培养基不妨一试,许多培养基可以适合多种细胞。
(3) 根据细胞株的特点、实验的需要来选择培养基。如小鼠细胞株多选RPMI1640 。
(4) 用多种培养基培养目的细胞,观察其生长状态,可以用生长曲线、集落形成率等指标判断,根据实验结果选择最佳培养基,这是最客观的方法,但比较繁琐。

2016年11月14日 上午 10:21 沙发
要是把常见细胞系与培养基类型对应起来,那就更好啦~